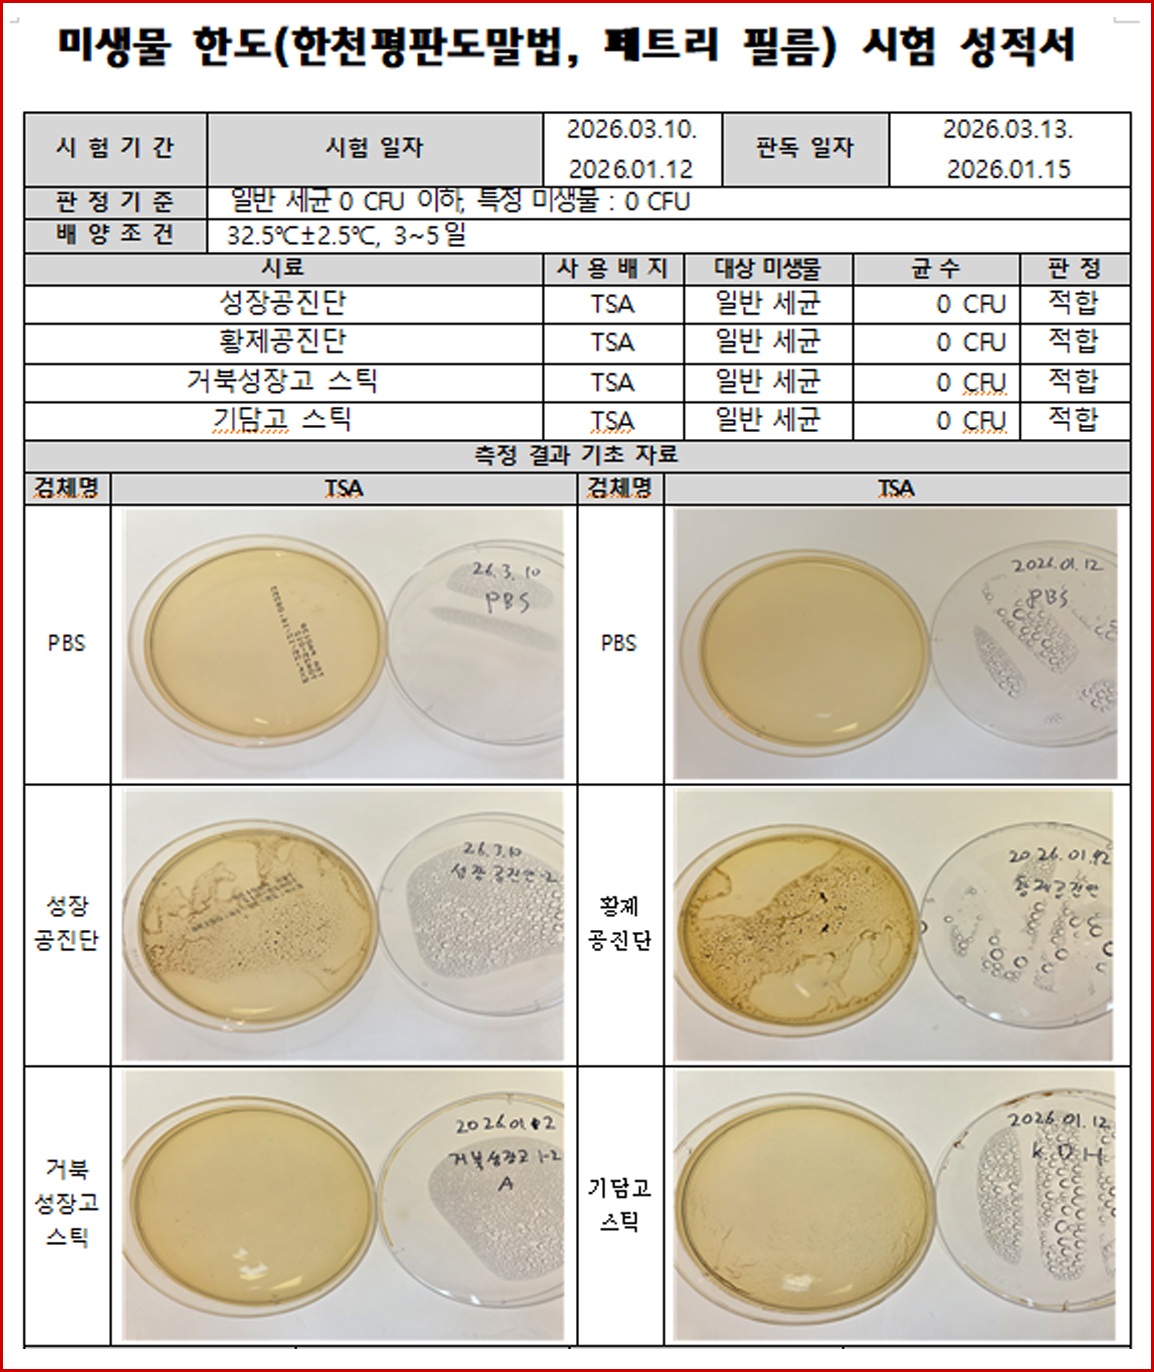
그래프1.jpg

속초17.0℃
속초17.0℃ 16.7℃
16.7℃ 철원17.1℃
철원17.1℃ 동두천19.4℃
동두천19.4℃ 파주16.6℃
파주16.6℃ 대관령15.3℃
대관령15.3℃ 춘천17.3℃
춘천17.3℃ 백령도7.6℃
백령도7.6℃ 북강릉20.5℃
북강릉20.5℃ 강릉22.9℃
강릉22.9℃ 동해17.2℃
동해17.2℃ 서울18.3℃
서울18.3℃ 인천15.6℃
인천15.6℃ 원주18.0℃
원주18.0℃ 울릉도17.1℃
울릉도17.1℃ 수원17.5℃
수원17.5℃ 영월17.3℃
영월17.3℃ 충주18.1℃
충주18.1℃ 서산17.5℃
서산17.5℃ 울진16.7℃
울진16.7℃ 청주18.8℃
청주18.8℃ 대전19.8℃
대전19.8℃ 추풍령20.0℃
추풍령20.0℃ 안동18.4℃
안동18.4℃ 상주20.0℃
상주20.0℃ 포항21.2℃
포항21.2℃ 군산19.5℃
군산19.5℃ 대구19.7℃
대구19.7℃ 전주20.3℃
전주20.3℃ 울산21.0℃
울산21.0℃ 창원19.9℃
창원19.9℃ 광주19.3℃
광주19.3℃ 부산20.8℃
부산20.8℃ 통영18.8℃
통영18.8℃ 목포18.7℃
목포18.7℃ 여수16.8℃
여수16.8℃ 흑산도16.8℃
흑산도16.8℃ 완도20.5℃
완도20.5℃ 고창20.2℃
고창20.2℃ 순천19.7℃
순천19.7℃ 홍성(예)19.6℃
홍성(예)19.6℃ 17.6℃
17.6℃ 제주19.9℃
제주19.9℃ 고산16.4℃
고산16.4℃ 성산18.6℃
성산18.6℃ 서귀포18.6℃
서귀포18.6℃ 진주20.8℃
진주20.8℃ 강화15.8℃
강화15.8℃ 양평15.9℃
양평15.9℃ 이천17.2℃
이천17.2℃ 인제17.2℃
인제17.2℃ 홍천17.8℃
홍천17.8℃ 태백18.2℃
태백18.2℃ 정선군19.3℃
정선군19.3℃ 제천17.6℃
제천17.6℃ 보은18.4℃
보은18.4℃ 천안18.5℃
천안18.5℃ 보령17.8℃
보령17.8℃ 부여18.9℃
부여18.9℃ 금산21.0℃
금산21.0℃ 18.1℃
18.1℃ 부안20.2℃
부안20.2℃ 임실19.9℃
임실19.9℃ 정읍20.7℃
정읍20.7℃ 남원19.3℃
남원19.3℃ 장수19.7℃
장수19.7℃ 고창군19.7℃
고창군19.7℃ 영광군18.9℃
영광군18.9℃ 김해시21.9℃
김해시21.9℃ 순창군20.1℃
순창군20.1℃ 북창원22.7℃
북창원22.7℃ 양산시22.4℃
양산시22.4℃ 보성군19.8℃
보성군19.8℃ 강진군20.3℃
강진군20.3℃ 장흥19.2℃
장흥19.2℃ 해남20.7℃
해남20.7℃ 고흥21.0℃
고흥21.0℃ 의령군19.5℃
의령군19.5℃ 함양군22.1℃
함양군22.1℃ 광양시19.9℃
광양시19.9℃ 진도군18.9℃
진도군18.9℃ 봉화18.7℃
봉화18.7℃ 영주17.8℃
영주17.8℃ 문경18.8℃
문경18.8℃ 청송군19.4℃
청송군19.4℃ 영덕20.1℃
영덕20.1℃ 의성19.0℃
의성19.0℃ 구미20.0℃
구미20.0℃ 영천18.5℃
영천18.5℃ 경주시21.6℃
경주시21.6℃ 거창20.7℃
거창20.7℃ 합천20.9℃
합천20.9℃ 밀양21.7℃
밀양21.7℃ 산청20.2℃
산청20.2℃ 거제19.7℃
거제19.7℃ 남해18.5℃
남해18.5℃ 21.5℃
21.5℃
2026년 04월 03일 (금)

![[자막뉴스] 서울시 한의약 치매 건강증진사업, 어르신 건강 증진에 한 몫](https://www.akomnews.com/data/photo/2512/990852453_gWjQvmYX_208ec3d22cca3c4dabe0690736cb02fecca2d1b0.jpg)
![[자막뉴스] 국회와 정부, K-MEDI 동행 선언](https://www.akomnews.com/data/photo/2512/990852453_pWMfBulG_1f19604ef50b802d08e2eba88760392f36a0c023.jpg)
![[자막뉴스] '2025 한의혜민대상' 원성호 서울대 보건대학교 교수 대상](https://www.akomnews.com/data/photo/2512/990852453_9aoWOQ7J_f562bba0ac6cd1fa3cb3e0cfa693448832494455.jpg)

![[여한의사회] "세계가 주목하는 침술의 힘"](https://www.akomnews.com/data/photo/2507/2039300137_tzacLJfB_2f59361a10063749b72d0e25ccb1a8ab9fe13f47.jpg)
























